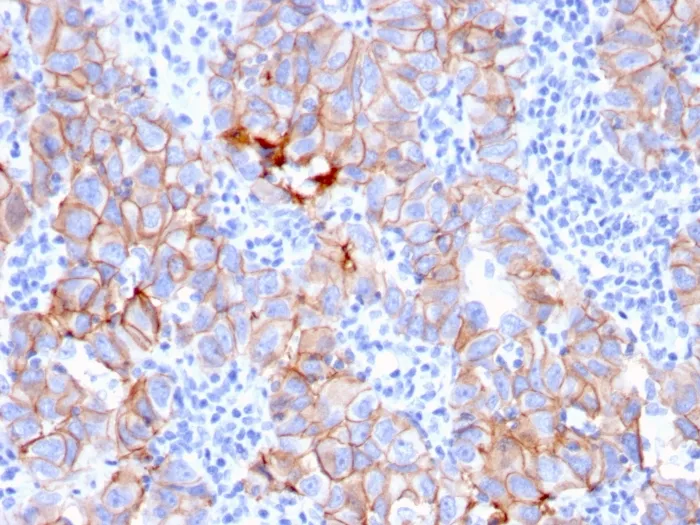

Anti-HER-2 / c-erbB-2 / neu / CD340(ERBB2/3080), CF740 conjugate
CAT:
37-BNC743080-100
Size:
100 µL
Price:
Ask
- Availability: 24/48H Stock Items & 2 to 6 Weeks non Stock Items.
- Dry Ice Shipment: No

Anti-HER-2 / c-erbB-2 / neu / CD340(ERBB2/3080), CF740 conjugate
- Description: Recognizes a protein of 185 kDa, which is identified as c-erbB-2/HER-2/neu. Its epitope is localized in the extracellular domain. C-erbB-2/HER-2 is a member of the EGFR family. This MAb is specific and shows minimal cross-reaction with other members of the EGFR-family. Receptors of this family are located on the plasma membrane and consist of an extracellular ligand-binding domain that is connected to a large intracellular domain by a single transmembrane sequence. c-erbB-2/HER-2 protein is over-expressed in a variety of carcinomas especially those of breast and ovary. Primary antibodies are available purified, or with a selection of fluorescent CF® Dyes and other labels. CF® Dyes offer exceptional brightness and photostability. Note: Conjugates of blue fluorescent dyes like CF®405S and CF®405M are not recommended for detecting low abundance targets, because blue dyes have lower fluorescence and can give higher non-specific background than other dye colors.
- Synonyms: p185; Verb b2 Erythroblastic Leukemia Viral Oncogene Homolog 2; Neuro/Glioblastoma Derived Oncogene Homolog
- CAS Number: 9007-83-4
- UNSPSC: 41116161
- UNSPSC Description: Primary and secondary antibodies for multiple methodology immunostaining detection application
- Gene Name: ERBB2
- Gene ID: 2064
- NCBI Gene ID: 446352
- UniProt: P04626
- Cellular Locus: Plasma membrane
- Host: Mouse
- Species Reactivity: Human
- Immunogen: Recombinant human HER-2 protein fragment (around aa 311-462) (exact sequence is proprietary)
- Target Antigen: c-ErbB-2 | CD340 | HER-2 | Neu
- Clonality: Monoclonal
- Isotype: IgG2b κ
- Clone: ERBB2/3080
- Conjugation: CF740
- Disease: Tumor
- Source: Animal
- Applications: IHC, FFPE (verified)
- Validated Applications: IHC, FFPE
- Positive Control: SKBR-3 cells. Breast cancer tissues.
- Concentration: 0.1 mg/mL
- Buffer: PBS, 0.1% rBSA, 0.05% azide
- Molecular Weight: 185 kDa
- Shipping Conditions: Room temperature
- Storage Conditions: 4°C; Protect from light; Stable at room temperature or 37°C (98°F) for 7 days.
- Shelf Life: 2 years